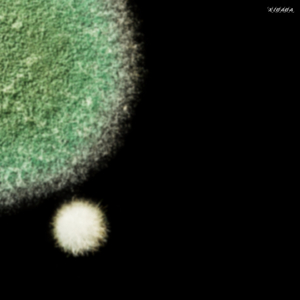
Deep Thoughts

Reverse Osmosis
AVXP
Deep Thoughts
Schuerfes

Ksr Reverse Osmosis Hook
Nmesh

Climb On (A Back That's Strong)
Reverse Osmosis

Proud Mary/Jet Airliner
Reverse Osmosis

Sweetness
Reverse Osmosis

Sugar (We're Going Down)
Reverse Osmosis

The District Sleeps Alone
Reverse Osmosis

I'd Do Anything for Love (But I Won't Do That)
Reverse Osmosis

Separate Ways (Worlds Apart)
Reverse Osmosis

One Angry Dwarf and 200 Solemn Faces
Reverse Osmosis

Fix You
Reverse Osmosis

Someone to Fall Back On
Reverse Osmosis

Deliver Me (Re-Recorded Version)
Reverse Osmosis

Reverse Osmosis (feat. Michael Romeo)
ICELAND, Michael Romeo

Reverse Osmosis
Alan Hamilton

My Record
Reverse Osmosis

Eat Me
Reverse Osmosis

No Way Out (Orignal Mix)
Reverse Osmosis

Its My Tribe (Orignal Mix)
Reverse Osmosis

BMRKJ Fly
Reverse Osmosis

Teach You to Groove (Orignal Mix)
Reverse Osmosis

Liquid (Orignal Mix)
Reverse Osmosis

Pressure (Monococ Remix)
Reverse Osmosis

Second Dream (Orignal Mix)
Reverse Osmosis

Just the Same (Orignal Mix)
Reverse Osmosis

Liquid (Orignal Mix)
Reverse Osmosis

Adishakti
Reverse Osmosis, Sneha Samra

Adishakti (Leonoel Remix)
Reverse Osmosis, Sneha Samra

Adishakti (Ind Ra Remix)
Reverse Osmosis, Sneha Samra

Half Full
Reverse Osmosis

Am A Copy Dog (David Phoenix Remix)
Reverse Osmosis

Move (Original Mxi)
Reverse Osmosis

Kai (Original Mix)
Reverse Osmosis

Am A Copy Dog
Reverse Osmosis

I Get Deep in Reverse (Koda AR Remix)
Reverse Osmosis

Am A Copy Dog (Xenia Liloo Remix)
Reverse Osmosis

Elfro
Reverse Osmosis

Phase Through
Reverse Osmosis

BMRKJ Scape (Orignal Mix)
Reverse Osmosis

Be Curious Not Judgemental
Reverse Osmosis

Eversince
Reverse Osmosis

Dancing the Desert
Reverse Osmosis

Quantum Shift
Reverse Osmosis

Let It Flow (Original Mix)
Reverse Osmosis

Intangible Cells
Reverse Osmosis

Darker Then the Night (Original Mxi)
Reverse Osmosis

Get Deep
Reverse Osmosis

Whats in the Name
Reverse Osmosis

Some Freaky
Reverse Osmosis

Be Loopy
Reverse Osmosis

Whooop !
Reverse Osmosis

Deep Rise (Original mix)
Reverse Osmosis

Tanhaiya
Reverse Osmosis

Change Is the Only Constant
Reverse Osmosis

Carbonic
Reverse Osmosis